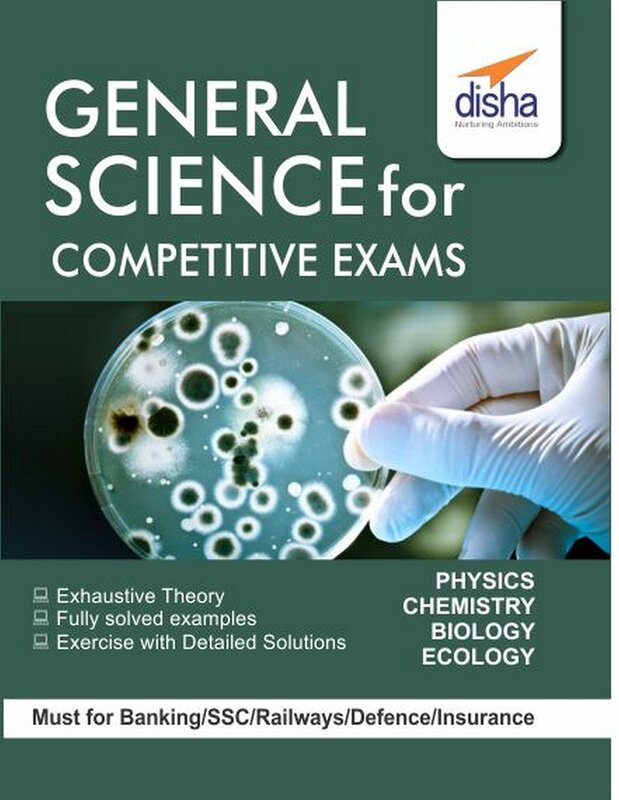

General Science for Competitive Exams
Details
Author
Disha Nurturing Ambitions Publisher
Disha Publication Items have been added to cart.
One or more items could not be added to cart due to certain restrictions.
- Can't add this product to the cart now. Please try again later.
- An error occurred. Please try again later.
- Can't delete this product from the cart at the moment. Please try again later.